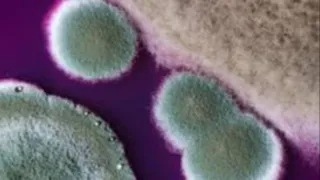
Debunking Mold Myths: Health Risks and Proper Removal

Simple, science-backed ways to reduce toxins, support your family’s health, and create a home where disease struggles to survive. Start with small changes that make a big impact. ...more
Blogs
March 19, 2026•4 min read

Feeling tired even though you’re drinking water? Learn why electrolytes matter for cellular hydration, energy, and clarity — no matter where you live. ...more
Blogs
February 13, 2026•3 min read


New Blog Post Description ...more
Blogs
March 28, 2025•6 min read


New Blog Post Description ...more
Blogs
August 26, 2024•2 min read

New Blog Post Description ...more
Blogs
July 18, 2023•4 min read

New Blog Post Description ...more
Blogs
July 18, 2023•2 min read


